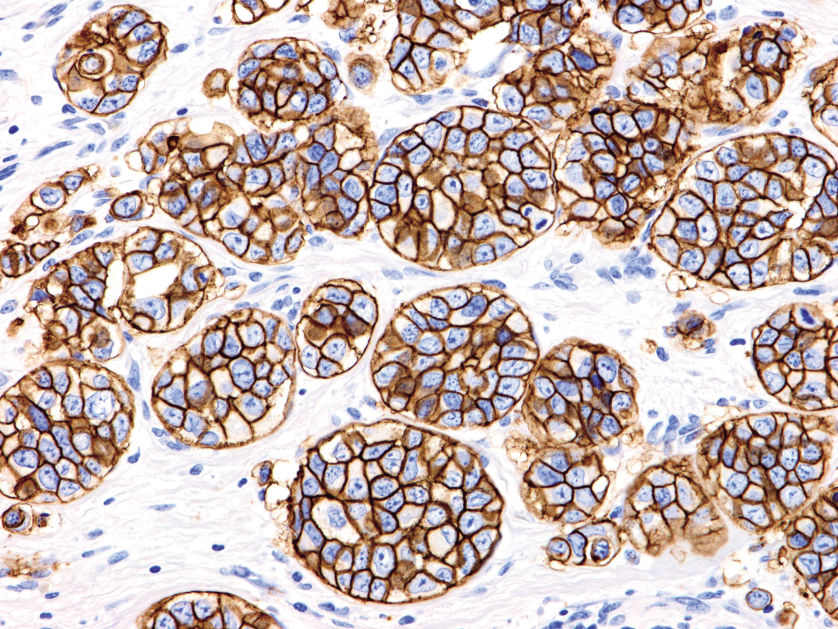

Microscopy
Nikon Upright Microscope
Ni Series

Nikon Upright Microscope
Ci Series

Nikon Upright Microscope
Si